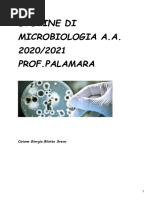

Patologia Generale
Caricato da
crane31Patologia Generale
Caricato da
crane31Universit Cattolica del Sacro Cuore Facolt di Medicina e Chirurgia A.
Gemelli
c
Corso di laurea in Terapia Occupazionale
Patologia Generale
appunti
-Danno cellulare - Adattamenti cellulari - Morte cellulare - Infiammazione
Simone COBETTO GHIGGIA
Universit Cattolica del Sacro Cuore Facolt di Medicina e Chirurgia A. Gemelli Corso di laurea in Terapia Occupazionale
Simone COBETTO GHIGGIA
matricola: 4051253 mail: simonecobettoghiggia@[Link] cell: 3775495873
Il danno cellulare pu essere dato da molteplici cause:
DANNO CELLULARE
l'ipossia, che pu essere ischemica (es: occlusione di un vaso con conseguente diminuzione di flusso ematico), ipossica (minor livelli di ossigeno nel plasma ematico) oppure da alterazioni del trasporto di ossigeno (es: avvelenamenti da CO)
agenti fisici, come la temperatura eccessivamente alta o bassa, la pressione atmosferica e le radiazioni saline-ipertoniche) agenti chimici e farmaci, (veleni, inquinanti ambientali e occupazionali, soluzioni agenti infettivi (virus, batteri, funghi, parassiti) reazioni immunologiche, molto importanti per l'organismo ma se eccessivamente stimolate possono causare gravi danni (es: la reazione anafilattica) alterazioni genetiche, malformazioni congenite (come la Sindrome di Down) o malattie monogeniche squilibri nutrizionali, come deficit calorico-proteici o eccessi nutritivi
Vi sono due tipologie di lesione cellulare: DANNO REVERSIBILE, indotto da risposte cellulari adattative che portano al raggiungimento di un nuovo equilibrio cellulare (vedi:adattamenti cellulari). In questa tipologia di danno cellulare si possono riscontrare: formazione di blobs sulla membrana cellulare, rigonfiamenti di membrana, disfunzione mitocondriale, una diminuzione dei reattivo) ed un aumento di livelli di calcio all'interno della cellula;
livelli di ATP, un aumento di permeabilit della membrana, di radicali liberi (ossigeno DANNO IRREVERSIBILE, in questo caso la cellula non si adatta e va incontro a necrosi o mitocondriale irreversibile, danni di membrana irreversibili e morte lisosomiale. ADATTAMENTI CELLULARI I meccanismi alla base degli adattamenti cellulari sono diversi, anzitutto lo stimolo pu agire direttamente o indirettamente sulla cellula bersaglio (nel secondo caso lo stimolo agisce sulle cellule limitrofe ad essa), inoltre su pu legare a recettori specifici presenti sulla superficie cambiamenti qualitativi e/o quantitativi di determinate proteine cellulari. cellulare innescando l'attivazione dei geni bersaglio, lo stimolo pu anche essere causa di
apoptosi (vedi:morte cellulare). Nel danno irreversibile si riscontrano una disfunzione
Universit Cattolica del Sacro Cuore Facolt di Medicina e Chirurgia A. Gemelli Corso di laurea in Terapia Occupazionale
Simone COBETTO GHIGGIA
matricola: 4051253 mail: simonecobettoghiggia@[Link] cell: 3775495873
Con il temine adattamento si intende: capacit delle cellule di modulare alcune delle proprie funzioni quando determinati eventi ne alterano l'equilibrio (omeostasi cellulare). Vi sono diverse tipologie di adattamenti cellulari: La METAPLASIA una tipologia di adattamento cellulare reversibile nel quale vi la sostituzione di un tipo cellulare ontogeneticamente differenziato con un altro tipo. Si parla di metaplasia squamosa quando vi il passaggio da epitelio cilindrico a epitelio stratificato (come nel caso di trachea e/o bronchi di un fumatore, oppure delle vie aeree in caso di deficit da vitamina A); la all'epitelio ghiandolare (es: l'esofago nella metaplasia di Barrett, nel quale aumenta la resistenza ai vi la formazione di cartilagine in tessuti che solitamente non la contengono ( il caso di alcuni muscoli in seguito a fratture ossee o traumi). Nelle cellule proliferanti si parla di iperplasia.
metaplasia squamosa inversa invece caratterizzata dal passaggio dall'epitelio pavimentoso succhi gastrici, ma diventa terreno fertile per le neoplasie); infine la metaplasia connettivale in cui
L' IPERPLASIA l'aumento di volume di un organo o tessuto causato da un maggior numero di cellule, si manifesta nei tessuti composti da cellule labili (cellule in grado di replicarsi e con (iperplasia ormonale) oppure se l'aumento del numero di cellule dovuto a un danno o proliferazione diventa eccessiva, dunque in caso di eccessiva proliferazione ormonale (in questo elevato turnover). E' di natura fisiologica se la proliferazione di tali cellule nella norma all'asportazione di un tessuto (iperplasia compensatoria). Diventa patologica quanto la caso si parla di iperplasia adenomatosa dell'endometrio in cui vi un eccesso di ormoni estrogeni prostatica in cui vi un eccesso di ormoni androgeni), o un'eccessiva produzione di fattori della cicatrizzazione).
con successivo sanguinamento e proliferazioni cancerose; oppure di iperplasia begnigna crescita ( il caso della cheiloide, eccessiva produzione di tessuto cicatriziale durante la
Nelle cellule quiescenti invece si parla di ipertrofia e ipotrofia (o atrofia).
L'IPERTROFIA l'aumento di volume di un organo o tessuto causato da un aumento delle sue dimensioni finalizzato ad un aumento delle capacit funzionali. L'aumento delle dimensioni non dovuto a un rigonfiamento cellulare ma da un'elevata sintesi delle componenti strutturali di essa (le cellule non sono di nuova generazione ma sono pi grandi), interessa i tessuti con cellule
perenni. Pu essere di natura fisiologica se l'aumento di dimensioni indotto da ormoni (ipertrofia ormonale associata a iperplasia), come nel caso della muscolatura liscia dell'utero in gravidanza (indotta da estrogeni) oppure nell'ipertrofia della mammella durante l'allattamento (indotta da
Universit Cattolica del Sacro Cuore Facolt di Medicina e Chirurgia A. Gemelli Corso di laurea in Terapia Occupazionale
Simone COBETTO GHIGGIA
matricola: 4051253 mail: simonecobettoghiggia@[Link] cell: 3775495873
prolattina ed estrogeni); o in seguito a un aumento della richiesta funzionale (ipertrofia della muscolatura stirata cardiaca e scheletrica negli atleti in seguito a stimoli meccanici e trofici _esercizio fisico) in cui l'aumento delle dimensioni avviene in seguito all'aumento di una singola fibra muscolare. Si tramuta in patologica quando l'aumento delle dimensioni dell'organo/tessuto risulta anormale o eccessivo (iperplasia del miocardio).
L'ATROFIA una riduzione di volume di un organo o tessuto causato da un diminuzione delle dimensioni delle sue cellule, generalmente di maggior entit nei tessuti non esistenziali (es: tessuto adiposo) rispetto ai tessuti di maggior importanza funzionale. E' fisiologica in caso di atrofia senile
(nei tessuti che contengono cellule perenni come i muscoli, il cervello e il cuore) o l'atrofia atrofie da di disuso, le atrofie ischemiche (atrofia degli AAII nella stenosi aortica) e le atrofie da compressione. MORTE CELLULARE
endocrina nell'epitelio vaginale e mammario in una donna in menopausa. Sono patologiche le
Il termine morte indica una cessazione irreversibile delle funzioni organizzate e coordinate che caratterizzano l'individualit biologica di un organismo. La morte caratterizzata da due aspetti: la progressiva disorganizzazione dell'architettura subcellulare e la graduale perdita delle funzioni elementari che ne mantengono gli equilibri metabolici e funzionali. Esistono due forme di morte cellulare, che differiscono per importanti aspetti della loro patogenesi: la necrosi e l'apoptosi. Esse hanno un ruolo differente nella fisiopatologia umana, essendo coinvolte in vari processi, come il danno tessutale da agenti esogeni, la morfogenesi, lo del sistema immunitario, la riparazione delle ferite ecc.
Caratteristiche Volume cellulare Nucleo Citoplasma Membrana cellulare Infiammazione Ruolo fisio-patologico NECROSI > PICNOSI CARIORESSI CARIOLISI (scomparsa del nucleo) Viene digerito o fuoriesce dalla cellula Danneggiata S Sempre patologico
sviluppo, il ricambio e l'invecchiamento dei tessuti, la genesi dei tumori, il controllo e la patologia Le principali differenze fra apoptosi e necrosi si riscontrano nelle seguenti caratteristiche:
APOPTOSI < Frammentazione Rimane intatto, viene secreto nei corpi apoptotici Integra NO 90% fisiologico, 10% patologico
Universit Cattolica del Sacro Cuore Facolt di Medicina e Chirurgia A. Gemelli Corso di laurea in Terapia Occupazionale
Simone COBETTO GHIGGIA
matricola: 4051253 mail: simonecobettoghiggia@[Link] cell: 3775495873
L'apoptosi una forma di morte cellulare attiva ben organizzata e controllata per la quale esistono all'organismo o danneggiate. Richiede una serie di eventi intracellulari coordinati e programmati. Letteralmente il termine apoptosi indica: apo-fuori e ptosi-caduta.
APOPTOSI
specifici markers morfologici e biochimici, destinata all'eliminazione di cellule indesiderate, inutili
In patologia, l'apoptosi si riscontra in stimoli fisici e chimici dannosi come la radioterapia, i farmaci citotossici antineoplastici (che danneggiano il DNA), malattie virali come l'epatite virale (in questa tipologia di epatite, l'eliminazione cellulare avviene principalmente per apoptosi), nell'atrofia patologica degli organi parenchimatosi dopo l'ostruzione di dotti (a carico di pancreas, regressione; ovvero nel 10% dei casi (il 90% fisiologica). Le principali alterazioni morfologiche sono: minor volume cellulare, condensazione della parotide e reni) e morte cellulare nelle neoplasie maggiormente in fase di crescita attiva e
cromatina, integrit della membrana plasmatica, comparsa di estroflessioni citoplasmatiche e corpi apoptopici. Essi vagano nell'organismo oppure vengono fagocitati da fagociti professionisti,
impedendo la risposta infiammatoria (risposta che al contrario avviene in seguito al procedimento necrotico). Le caratteristiche biochimiche dell'apoptosi sono le CASPASI (Cytosolic Aspartate Specific
Proteases), enzimi presenti in tutte le cellule come intattivi (attivati nell'apoptosi), dediti al taglio delle proteine all'altezza dell'acido aspatico, sono responsabili della digestione delle proteine citoscheletriche (sono dunque le responsabili dell'alterazione della forma cellulare), delle proteine della matrice nucleare (sono dunque le responsabili della frammentazione del nucleo) e dell'inibitore della DNASI (sono dunque le responsabili del taglio internucleosomico del DNA).
L'apoptosi si articola in tre fasi: In queste fase viene innescato il processo apoptotico (CASPASI 8 e 9). 1. INIZIO e si attivano le CASPASI INIZIATRICI
La CASPASI da iniziatrici (8 e 9) diventano EFFETTRICI (3 e 6), una volta attivate si occupano della
2. FASE EFFETTRICE
Universit Cattolica del Sacro Cuore Facolt di Medicina e Chirurgia A. Gemelli Corso di laurea in Terapia Occupazionale
Simone COBETTO GHIGGIA
matricola: 4051253 mail: simonecobettoghiggia@[Link] cell: 3775495873
frammentazione idrolitica delle proteine; si formano dei legami crociati fra proteine in reazione alle transglutaminasi; si formano dei legami crociati fra proteine in reazione alle transglutaminasi; viene rotto il DNA; infine vi una ricognizione fagocitaria durante la quale le macrofagi e facilitare dunque la loro fagocitosi. cellule fagocitate espongono l'antigene sulla membrana plasmatica rendendosi riconoscibili per i Avviene dunque in questa fase la morte cellulare per apoptosi in quanto le CASPASI dividono delle proteine citoscheletriche, le proteine della matrice nucleare e gli inibitori della DNASI del nucleo e il taglio internucleosomico del DNA. 3. RIMOZIONE DELLE CELLULE MORTE I corpi apoptotici (corpi delle cellule morte per apoptosi) vengono eliminati per fagocitosi da parte dei macrofagi prima di andare incontro a necrosi, in modo tale da evitare la risposta infiammatoria. I mitocondri hanno un ruolo fondamentale nei processi apoptotici in quanto: aumentando i pori presenti sulla membrana cellulare, si gonfiano e inducono una diminuzione del potenziale di membrana, dunque un innalzamento della permeabilit di essa, infine attivano le CASPASI (che inducono il processo apoptotico). L'inibizione dell'apoptosi induce una maggior sopravvivenza delle cellule, se tali cellule risultano anormali si va incontro a cancro, mentre se non vi l'eliminazione dei linfociti autoreattivi alla fine di una reazione immunitaria si di fronte ad una malattia autoimmune. citoplasmatica determinando rispettivamente alterazioni della forma cellulare, la frammentazione
L'aumento di apoptosi invece induce l'eccessiva morte cellulare, sviluppando dunque malattie neurodegenerative (in caso di perdita di cellule normali o con funzione difensiva), danno ischemico (come nel caso di infarto del miocardio) o deplezione dei linfociti indotta da virus (AIDS)
La necrosi un processo di morte cellulare, data da una gamma di alterazioni morfologiche che seguono la morte di pi cellule di un tessuto od organo all'interno di un organismo vivente, il enzimatica, induce una risposta infiammatoria da parte dell'organismo. risultato di processi degradativi e di denaturazione proteica in cui domina la digestione
NECROSI
Universit Cattolica del Sacro Cuore Facolt di Medicina e Chirurgia A. Gemelli Corso di laurea in Terapia Occupazionale
Simone COBETTO GHIGGIA
matricola: 4051253 mail: simonecobettoghiggia@[Link] cell: 3775495873
La membrana cellulare non viene mantenuta integra durante i processi necrotici, la cellula perde dunque i contorni ed il liquido intracellulare diventa extracellulare inducendo la risposta infiammatoria (vedi: infiammazione).
La digestione enzimatica pu avvenire per AUTOLISI, se ad opera di enzimi prodotti dai lisosomi propri della cellula morta, oppure per ETEROLISI se la digestione enzimatica opera di enzimi prodotti dai lisosomi dei leucociti sopraggiunti. Vi sono diversi tipologie di necrosi: NECROSI COAGULATIVA nella quale vi una denaturazione delle proteine strutturali ed enzimatiche dovuta all'occlusione dei vasi sanguigni che irrorano l'organo interessato, in cui la struttura generale delle cellule resta visibile per giorni (es: infarto del miocardio); NECROSI COLLIQUATIVA, ovvero digestione enzimatica delle cellule morte che pu avvenire per autolisi (enzimi rilasciati dalle stesse cellule enzimatiche) o eterolisi (enzimi rilasciati dalle cellule infiammatorie attivate), in questo caso la struttura generale e l'architettura della cellula subiscono notevoli modificazioni durante il processo necrotico; NECROSI CASEOSA, insieme delle precedenti tipologie nella quale l'architettura tissutale risulta irriconoscibile (tipica della TBC). INFIAMMAZIONE L'infiammazione la risposta aspecifica al danno vascolare e connettivale del tessuto leso quello di recapitare leucociti e plasma nella sede del danno in modo tale da avviare processi che (provocato da agenti chimici, fisici o biologici), che pu essere di tipo acuta o cronica, il cui scopo circoscrivono e combattono l'agente lesivo, riparano il danno causato e rimuovono le cellule prostaglandine, trombossani, leucotrieni, PAF _fattore attivante le piastrine, citochine, NO _ossido
necrotiche, controllata dall'azione (produzione e liberazione) di mediatori chimici (istamina,
di azoto, sistema del complemento, della coagulazione e delle chinine).
Gli attori principali coinvolti nell'infiammazione sono cellule del tessuto connettivo (mastociti, fibroblasti, macrofagi, collagene, laminina, fibronectina, proteoglicani), cellule presenti nei vasi (membrana basale). sanguigni (neutrofili, linfociti B e T, monociti, eosinofili, bAsofili) e cellule della matrice
I sintomi caratteristici dell'infiammazione sono 5: DOLOR
dolore
dovuto alle alterazioni biochimiche locali
Universit Cattolica del Sacro Cuore Facolt di Medicina e Chirurgia A. Gemelli Corso di laurea in Terapia Occupazionale
Simone COBETTO GHIGGIA
CALOR
calore
matricola: 4051253 mail: simonecobettoghiggia@[Link] cell: 3775495873
aumento della temperatura corporea dovuto all'aumento della quantit di sangue nell'area di lesione rigonfiamento cutaneo arrossamento cutaneo dovuto all'aumento della quantit di sangue nell'area lesa compromissione funzionale della zona lesa EFFETTI SISTEMICI
TUMOR RUBOR FUNCTIO LESA
edema rossore
Innalzamento della temperatura corporea fisiologica (37C) e particolare forma di ipertermia in quanto si tratta di un'alterazione funzionale reversibile dai neuroni dei centri termoregolatori ipotalamici. Pu essere continua, remittente o alternare periodi di continuit e remittenza (continua-remittente). Pu essere causata da AGENTI PIROGENI ESOGENI (proditti all'esterno dell'organismo come endotossine batteriche, molecole appartenenti a virus o batteri, farmaci o composti di natura non proteica) che incidono sull'aumento di temperatura in maniera secondaria in quanto, una volta inseriti nell'organismo attivano gli agenti pirogeni endogeni; o da AGENTI PIROGENI ENDOGENI (prodotti all'interno dell'organismo come le citochine TNF e IL-1 che sono prodotte dai neutrofili e i macrofagi) che agiscono direttamente sull'innalzamento della temperatura corporea e causano la sintesi degli agenti pirogeni esogeni. Gli agenti pirogeni esogeni attivano gli agenti pirogeni endogeni i quali a inviano stimoli all'encefalo mediante la circolazione ematica (processo di ciclo-ossigenasi), il cervello invia impulsi attraverso prostaglandine ai i neuroni ipotalamici, vengono attivati i neuroni ipotalamici dunque la sensibilit neuronale e la temperatura corporea (>37C). Il decorso della febbre si articola in tre fasi: 1, RIALZO TERMICO dei centri termoregolatori che inviano segnali intracellulari di inibizione neuronale, aumentano
FEBBRE
fase prodromica I neuroni ipotalamici (una volta ricevuto l'impulso dall'encefalo) inviano stimoli termici per aumentare la temperatura corporea (risposta termoconservativa). In questa fase si percepisce la sensazione di freddo e si osservano il pallore cutaneo e brividi.
Universit Cattolica del Sacro Cuore Facolt di Medicina e Chirurgia A. Gemelli Corso di laurea in Terapia Occupazionale
Simone COBETTO GHIGGIA
matricola: 4051253 mail: simonecobettoghiggia@[Link] cell: 3775495873
2, FASTIGIO La temperatura si stabilizza oltre i 37C e rimane costante finch non cessa la produzione di citochine pirogene (prostaglandine). Il sintomo percepito in questa fase la sensazione di caldo. 3,DEFERVESCENZA
Vi un abbassamento della temperatura fino ad ritornare alla condizione fisiologica di 37C, tale abbassamento dovuto alla riduzione di agenti pirogeni endogeni e prostaglandine attivi, dunque i neuroni rientrano nella condizione normale di sensibilit agli stimoli termici. del soggetto. PROTEOLISI MUSCOLARE La febbre protratta nel tempo provoca un aumento del catabolismo proteico e dunque astenia, dolori muscolari. LEUCOCITOSI Ovvero un aumento dei globuli bianchi presenti nell'organismo che acquisisce nomi differenti a seconda dei globuli bianchi interessati (es: GB neutrofili Neutrofilia, GB eosinofili Eosinofilia, etc...) I sintomi percepiti in questa fase sono la sensazione di caldo e pu esserci sudorazione da parte
VES - Test che misura la velocit impiegata dai globuli rossi per dividersi dal plasma per depositandosi sul fondo della provetta. nel sangue. GUARIGIONE DEI TESSUTI Durante l'infiammazione la VES aumenta perch il numero delle proteine di fibrinogeno aumenta
AUMENTO DELLA Velocit di Eritro-Sedimentazione
La guarigione tissutale un fenomeno complesso, ordinato e coordinato che consiste nel ripristino delle strutture originali con deposito di collagene e/o tessuto cicatriziale (cicatrici). Coinvolge i seguenti processi: 1. Induzione del processo infiammatorio acuto dovuto alla lesione iniziale 2. Iperplasia compensatoria delle cellule parenchimali del tessuto (inizio della proliferazione) 3. Migrazione delle cellule parenchimali e del tessuto connettivo nella sede della lesione
Universit Cattolica del Sacro Cuore Facolt di Medicina e Chirurgia A. Gemelli Corso di laurea in Terapia Occupazionale
Simone COBETTO GHIGGIA
matricola: 4051253 mail: simonecobettoghiggia@[Link] cell: 3775495873
4, Sintesi delle proteine appartenenti alla matrice extracellulare 5. Rimodellamento delle componenti del tessuto connettivo e parenchimale 6. Riorganizzazione del collagene deposto 7. Acquisizione della resistenza meccanica RIPARAZIONE DEI TESSUTI
Organi/Tessuto Epiteli e Mucose - ferite cutanee (es: ulcere) Miocardio Tessuto Osseo SNC Infarto Fratture - Ictus (lesioni ischemiche) - Infezioni (meningiti) - Lesioni Fegato - Lesioni da virus o agenti tossici - Resezioni - Trapianti - Gangrene EPATONTI, Cellule STELLATE EPATICHE, Cellule di KUPFFER Cellule varie Cellule MESENCHIMALI (miocardiche) OSTEOBLASTI Cellule NEURONALI e Cellule GLIALI Evento Cellule coinvolte nei processi di riparazione - lesioni del tratto gastro-intestinale Cellule EPITELIALI
Impalcatura essenziale per la guarigione e la riparazione delle ferite, secreta localmente, si organizza a formare una rete negli spazi che circondano le cellule. Ha il compito di mantenere la corretta polarit cellulare per la ricostruzione delle strutture
ECM Matrice Extra Cellulare
pluristratificate, inoltre funge da magazzino dei fattori di crescita che regolano la proliferazione cellulare, un elemento molto importante per le interazioni fra cellule e funge da substrato per l'adesione, la migrazione e la proliferazione delle cellule. In collaborazione con altre proteine, allo scheletro dei tessuti. sequestra l'ossigeno per garantire il turgore dei tessuti molli e fornire i minerali che danno rigidit
composta da collagene, elastina (proteine fibrose tissutali), glicoproteine di adesione, strutture differenti: la matrice interstiziale e la membrana basale.
proteoglicani e acido ialuronico. I suoi componenti si organizzano in modo da formare due
Universit Cattolica del Sacro Cuore Facolt di Medicina e Chirurgia A. Gemelli Corso di laurea in Terapia Occupazionale
Simone COBETTO GHIGGIA
matricola: 4051253 mail: simonecobettoghiggia@[Link] cell: 3775495873
La riparazione delle ferite cutanee (dermo-epidermiche) avviene nel seguente modo: 1. Lesione tissutale 2. Formazione del coagulo intervengono fibrina e fibronectina
3. Iperplasia delle cellule parenchimali
a livello sottcutaneo vi proliferazione e migrazione cellulare e rimodellamento dell'ECM
4. Infiltrazione del PMNL e dei Leucociti 5. Si instaura il tessuto di granulazione
fagocitano e danno vita alle GFs e CKs (chetochine) avvengono i processi di angiogenesi, sintesi e deposizione di ECM, rimodellamento ed acquisizione della resistenza alla lesione
Aspetti Patologici nella Riparazione di FERITE CUTANEE Da formazione di tessuto cicatriziale INSUFFICIENTE DEISCENZA della ferita ULCERAZIONI Da formazione di tessuto cicatriziale ECCESSIVA CICATRICI IPETROFICHE (CHELOIDI) Nuova rottura (riapertura) della medesima lesione Condizione di inadeguata circolazione Dipendono dalla predisposizione dell'individuo (individui predisposti: persone di colore, persone fortemente pigmentate, persone che hanno subito TESSUTO CICATRIZIALE ECCESSIVO Formazione di FIBROMATOSI AGGRESSIVE Tumori interventi chirurgici o notevoli ustioni)
Aspetti Patologici nella Riparazione di FERITE NON CUTANEE Problema: PERSISTENZA DELLO STIMOLO LESIVO FIBROSI SCLEROSI CIRROSI Abbondanza di tessuto connettivo in organi o tessuti senza rilevanti alterazioni nei rapporti con l'ECM Eccesso della componente stromale di un organo con lenta evoluzione verso il tessuto connettivo fibroso Sclerosi associata a Iperplasia compensatoria NON coordinata alla parenchima del tessuto interessato
Universit Cattolica del Sacro Cuore Facolt di Medicina e Chirurgia A. Gemelli Corso di laurea in Terapia Occupazionale
Simone COBETTO GHIGGIA
matricola: 4051253 mail: simonecobettoghiggia@[Link] cell: 3775495873
INFIAMMAZIONE ACUTA 1, VASOCOSTRIZIONE FASI
Vasocostrizione delle arteriole pre-capillari, transitoria, incostante e breve (pu dirare da pochi secondi a qualche minuto), non avviene sempre. 2, VASODILATAZIONE
Inizia dalle arteriole per aprire nuovi letti capillari, la dilatazione dei vasi data dal rilascio di sfinteri (gruppi di cellule muscolari presenti nella biforcazione delle arteriole pre-capillari). In questa fase aumenta la quantit di sangue presente nel tessuto, si parla dunque di iperemia attiva in quanto richiesto l'intervento della muscolatura liscia dei vasi e si presentano due sintomi caratteristici dell'infiammazione: CALOR (calora dovuto all'aumento della temperatura) e RUBOR (rossore dovuto all'aumento di sangue). 3. FORMAZIONE DELL'ESSUDATO [segno distintivo dell'infiammazione acuta]
Vi fuoriuscita di liquido dai vasi per aumentata PRESSIONE ONCOTICA IDROSTATICA e permeabilit capillare (evento contemporaneo alla vasodilatazione). In questa fase si presentano il TUMOR (essudazione/edema infiammatorio) e il DOLOR (dovuto alla compressione delle terminazioni nervose) (parentesi sull'essudato)
L'ESSUDATO un accumulo di liquidi (ad elevata concentrazione proteica) derivati dal plasma ematico nel tessuto extravascolare, per questo motivo possibile che nei detriti vi siano tracce di dei vasi. [tipico dell'infiammazione acuta] 4. STASI sangue. presente solo in caso di alterato equilibrio pressorio associato all'aumentata permeabilit
Avviene in seguito alla fuoriuscita dei liquidi (essudato) e delle cellule (diapedesi). Vi sono una maggior viscosit del sangue e una decelerazione del flusso ematico (l'aumentata concentrazione di globuli rossi nei piccoli vasi e la maggior viscosit ematica spingono i leucociti verso la parete dei vasi, essi fuoriescono e causano tale decelerazione).
Universit Cattolica del Sacro Cuore Facolt di Medicina e Chirurgia A. Gemelli Corso di laurea in Terapia Occupazionale
Simone COBETTO GHIGGIA
matricola: 4051253 mail: simonecobettoghiggia@[Link] cell: 3775495873
5. DIAPEDESI DEI LEUCOCITI I leucociti sono portati nella sede della lesione dove svolgono la loro azione difensiva nei confronti dell'organismo. Tale procedimento avviene attraverso diversi punti: 1. Migrazione, Rotolamento e Adesione _dei leucociti all'endotelio (i leucociti sono spinti verso la parete dell'endotelio alla quale vi aderiscono grazie a legami con molecole di adesione complementari presenti sia sul leucocita che sulla parete dell'endotelio) _tali mucina-simili molecole di adesione sono: selectine, integrine, immunoglobuline (Img) e glicoproteine 2. Diapedesi _ovvero migrazione dell'endotelio verso il tessuto extravascolare. Tale migrazione avviene il movimento del leucocita dalla parete del vaso verso il tessuto nel tessuto e mastociti che rispondono al danno secernendo esse) 3. Chemiotassi Le CHEMOCHINE guidano e attirano il leucocita all'interno della cellula, mentre le CITOCHINE (una volta che il leucocita ha inglobato il batterio) sono inviate dal leucocita stesso a preparare il leucocita infetto in modo tale da permetterne l'uscita. A questo punto gli enzimi degradanti (COLLAGENASI e METALLO PROTEASI) degradano la membrana cellulare per permettere al leucocita di uscire e andare incontro a chemiotassi. 6, FAGOCITOSI La fagocitosi data dalla capacit di alcuni tipi cellulari (FAGOTICI PROFESSIONISTI, ovvero FACOLTATIVI, che dunque fagocitano solo se attivati da uno stimolo, come nel caso dei fibroblasti, dei mastociti e delle cellule endoteliali) di ingerire ed eliminare materiali estranei. Si articola in tre fasi: fagociti dediti esclusivamente a fagocitare come i neutrofili, monociti e macrofagi e FAGOCITI extravascolare ad opera di CITOCHINE e CHEMOCHINE (prodotte da macrofagi presenti
1. Riconoscimento e Adesione _in questa fase i recettori di membrana interagiscono con i ligandi presenti sulla superficie del batterio, questo procedimento risulta di maggior efficacia se il batterio in questione opsonizzato (OPSONINE: specifiche proteine molto mediata dal legame fra il recettore e la particella da fagocitare.
affini per i fagociti). Il fagocita riconosce dunque la particella e vi aderisce, tale adesione 2. Ingestione _ il fagocita (una volta riconosciuta la particella ed aderitovi) emette pseudopodi che inglobano la particella. Una volta che la particella viene inglobata al 100%
Universit Cattolica del Sacro Cuore Facolt di Medicina e Chirurgia A. Gemelli Corso di laurea in Terapia Occupazionale
Simone COBETTO GHIGGIA
matricola: 4051253 mail: simonecobettoghiggia@[Link] cell: 3775495873
dagli pseudopodi si crea il FAGOSOMA (vescicola rivestita da membrana che contiene il materiale fagocitato), all'interno del quale vengono liberati enzimi lisosomiali e si procede con la mutazione del fagosoma in FAGOLISOSOMA (fagosoma fuso ai lisosomi del fagocita).
3. Uccisione _ l'uccisione del fagolisosoma pu avvenire tramite DIGESIONE (gli enzimi lisosomiali digeriscono il materiale fagocitato, ci che resta in seguito a questo procedimento viene riversato all'esterno della cellula per esocitosi) o attraverso dovuti all'aumentato consumo di ossigeno durante la fagocitosi) 7. RISOLUZIONE DELL'INFIAMMAZIONE L'infiammazione acuta pu terminare con la restitutio ad integrum dei tessuti danneggiati (risoluzione al 100%), o con la riparazione di essi (sostituzione con tessuto cicatriziale _cicatrice), oppure con la cronicizzazione dell'infiammazione (se la causa infiammatoria persiste nel tempo, si ha il passaggio da infiammazione acuta a cronica) TIPI I diversi tipi di infiammazione acuta si distinguono attraverso l'essudato che presentano, le diverse tipologie sono le seguenti: sierosa, fibrinosa, emorragica, catarrale, pseudomembranosa, gangrenosa e purulenta. L'infiammazione SIEROSA interessa i tessuti lassi come i tessuti sottocutanei, i tessuti oculari e liquida, ci comporta la presenza di un notevole edema. (vedi: infiammazione cronica)
MECCANISMI OSSIGENO-DIPENDENTI (formazione di reattivi intermedi dell'ossigeno
quelli dello scroto ed caratterizzata da essudato povero di cellule e con elevata componente
L'infiammazione FIBRINOSA interessa i tessuti polmonari e delle membrane sierose come il essudato ricco di cellule ematiche (conseguenza di una rottura o danno dei vasi, ovvero un'emorragia).
peritoneo, il pericardio e la pleura (peritone-ite, pericard-ite e pleur-ite), caratterizzata da
L'infiammazione CATARRALE interessa i tessuti delle mucose secernenti muco (il muco viene secreto in difesa contro virus o batteri), l'essudato si presenta dunque ricco di muco (es: raffreddore comune).
Universit Cattolica del Sacro Cuore Facolt di Medicina e Chirurgia A. Gemelli Corso di laurea in Terapia Occupazionale
Simone COBETTO GHIGGIA
matricola: 4051253 mail: simonecobettoghiggia@[Link] cell: 3775495873
L'infiammazione PSEUDOMEMBRANOSA interessa anch'essa le mucose, si presenta con la formazione di una pseudomembrana costituita da tessuto necrotico ed essudato flogistico (essudato infiammatorio).
L'infiammazione GANGRENOSA (che presenza gangrena) si manifesta con necrosi molto estese (pu ad esempio interessare l'intero AS DX), si presenta quando (durante l'infiammazione acuta) si impiantano particolari batteri all'interno del tessuto necrotico. L'infiammazione PURULENTA causata da batteri piogeni, in questa tipologia di infiammazioneil centro della lesione infiammata diventa una cavit ricca di pus, contenente tessuto necrotico e polimorfonucleati. In questo caso si pu notare la formazione di uno o pi ascessi. edemi con fibrina, microrganismi vivi e morti e materiale necrotico) MEDIATORI CHIMICI (ASCESSO_ cumulo doloroso di pus causato da infezione batterica, ricco di leucociti vivi e morti,
Sono molecole che scatenano, mantengono e limitano i fenomeni tipici dell'infiammazione, per lo la maggior parte sono potenzialmente dannosi per l'organismo, la loro produzione scatenata da prodotti microbici e proteine dell'ospite, una volta attivati hanno vita breve, mentre la loro azione biologica avviene grazie a legami con specifici recettori presenti sulle cellule bersaglio. Hanno effetti di AMPLIFICAZIONE (stimolano il rilascio di altri mediatori da parte delle cellule bersaglio), di MODULAZIONE e REGOLAZIONE (agiscono sulle cellule bersaglio con un obiettivo specifico).
Vi sono di diversi tipi di mediatori chimici, ognuno dei quali con caratteristiche specifiche. solamente in seguito a specifici stimoli infiammatori.
I MEDIATORI PRE-FORMATI ad esempio, sono contenuti in organuli cellulari e vengono rilasciati Appartengono a questa categoria l'ISTAMINA (responsabile della vasodilatazione, prodotta da organi basofili e mastociti tissutali in seguito alla degranulazione esplosiva data dallo stimolo flogistico) che nel microcircolo apre gli sfinteri pre-capillari formati da muscolatura liscia e
stimola il rilascio di NO (ossido di azoto) aumentando la permeabilit capillare delle venule e la contrazione delle cellule endoteliali, mentre nel macrocircolo induce la contrazione della dell'ACIDO CLORIDRICO (subrstrato degli enzimi ciclossigenasie ipossigenasi) quali le muscolatura liscia causando bronospasmi e la contrazione delle grandi arterie; i METABOLITI
Universit Cattolica del Sacro Cuore Facolt di Medicina e Chirurgia A. Gemelli Corso di laurea in Terapia Occupazionale
Simone COBETTO GHIGGIA
matricola: 4051253 mail: simonecobettoghiggia@[Link] cell: 3775495873
PROSTAGLANDINE (responsabili della vasodilatazione, dell'aumentata permeabilit dei vasi e della dell'aggregazione plasmatica) e i LEUCOTRIENI (responsabili della costrizione bronchiale, della chemiotassi dei neutrofili e degli eosinofili); il PAF (Fattore Attivante le Piastrine) prodotto dai mastociti, neutrofili, monociti, piastrine ed endotelio, a bassa concentrazione responsabile della chemiotassi dei leucociti. I MEDIATORI DI NUOVA SINTESI sono sintetizzati e secreti solamente in seguito alla repressione genica, innescata da precisi stimoli flogistici (flogosi), fra di essi si trovano le CITOCHINE (MONOCHINE, LINFOCHINE, INTERLEUCHINE -IL-, CHEMOCHINE), molecole di segnalazione intracellulare prodotte da diverse tipologie di cellule (linfociti, macrofagi attivati, cellule endoteliali, epiteliali e del tessuto connettivo) che modulano la funzione di altre cellule (a breve distanza agiscono in maniera autocrina in quanto agiscono sulla stessa cellula che le ha prodotte, mentre a lunga distanza agiscono in modalit paracrina, agiscono dunque su cellule diverse da particolare le IL agiscono principalmente sui leucociti e le CHEMOCHINE condividono la quelle che le hanno create), sono inoltre coinvolte nell'infiammazione e nell'immunit, in comparsa del dolore), i TROMBOSSANI (responsabili della vasocostrizione e
vasodilatazione, mentre ad alta concentrazione induce la vasocostrizione provocando la
chemiocinesi (capacit di stimolare la motilit cellulare), la chemiotassi (capacit di stimolare il movimento orientato) dei leucociti ; il NO (Ossido di Azoto), gas solubile prodotto dalle cellule endoteliali, dai macrofagi e dai neuroni, che provoca vasodilatazione agendo sulla muscolatura liscia dei vasi, controlla le reazioni infiammatorie (meccanismo compensatorio endogeno) inibendo il rotolamento e l'adesione dei leucociti all'endotelio e ha un ruolo microbico in quanto partecipa all'eliminazione dei batteri all'interno del fagolisosoma.
I MEDIATORI DI FASE FLUIDA, si fermano nel sangue e sono formati da precursori inattivi che sistemi fra interconnessi fra di loro, basati su uno schema di attivazione comune.
vengono attivati in seguito a tagli proteici ( i tagli proteici dipendono dalle caspasi ), sono tre Il SISTEMA DEL COMPLEMENTO, che si occupa della difesa dell'organismo dai microrganismi, formato da 20 proteine le quali causano l'aumento della permeabilit vascolare, la chemiotassi dei leucociti e l'opsonizzazione dei batteri. presente nel plasma ematico sotto forma di proteina inattive (C1 e C9), tali proteine vengono attivate da un processo enzimatico a cascata indotto dal taglio proteico (causato dall'azione delle caspasi) che si interrompe solo alla comparsa di un complesso di attacco della membrana (MAC) che induce la morte di batteri e virus. Il sistema del complemento inoltre importante perch, nell'attivarsi si creano alcuni frammenti che
Universit Cattolica del Sacro Cuore Facolt di Medicina e Chirurgia A. Gemelli Corso di laurea in Terapia Occupazionale
Simone COBETTO GHIGGIA
matricola: 4051253 mail: simonecobettoghiggia@[Link] cell: 3775495873
contribuiscono all'innescare e ampliare certi tipi di reazioni infiammatorie (infiammazione acuta). Gli enzimi inibitori presenti nel sangue limitano l'auto-attivazione del complesso. Il sistema del DELLA LECTINA), tutte danno come risultato il MAC (Complesso di Attacco della Membrana). complemento presenta tre differenti modalit di attivazione (VIA CLASSICA, VIA ALTERNATA, VIA Il SISTEMA DELLA COAGULAZIONE avviene attraverso l'azione delle proteine della coagulazione, responsabili dell'emostasi. L'emostasi avviene in tre fasi: 1) coagulazione dei vasi della muscolatura liscia, 2) formazione del tappo piastrinici (emostasi primaria) e 3) formazione del coagulo (emostasi secondaria). Il SISTEMA DELLE CHININE, dato dall'attivazione del fattore XII di Hagerman, si occupa del dividere la callicreina, agisce sul chininiogeno ad alto peso molecolare favorendo la vasodilatazione e dando origine alla bradichinina, inoltre taglia la plasmina dando origine alla fibrina. ESITI Gli esiti dell'infiammazione variano a seconda delle cause infiammatorie:
CAUSA Infarto Infezione batterica Tossine o Traumi EFFETTO Alterazioni vascolari Reclutamento dei neutrofili Attivazione di mediatori
E' causata da INFEZIONI PERSISTENTI (TBC o Sifilide), ESPOSIZIONE PROLUNGATA AD AGENTI TOSSICI (Silicosi, Cirrosi, Arteriosclerosi) o AUTOIMMUNIT (Reazioni autoimmuni o Reazioni di ipersensibilit).
INFIAMMAZIONE CRONICA
Le caratteristiche principali sono: l'INFILTRAZIONE DI CELLULE MONONUCLEATE (macrofagi, linfociti e plasmacellule), DANNO TESSUTALE e VANI TENTATIVI DI RIPARAZIONE di tessuti danneggiati. Le cellule coinvolte nell'infiammazione cronica sono: MACROFAGI (componenti dei fagociti mononucleati, sono monociti presenti nel tessuto intracellulare che durante le prime 48h dell'infiammazione acuta fuoriescono nel tessuto extracellulare trasformandosi) che hanno il compito di fagocitare e dunque eliminare i batteri e le cellule infette da virus, rilasciare citochine pro-infettive, proteine di fase acuta e fattori coinvolti nella respirazione cellulare, presentare
Universit Cattolica del Sacro Cuore Facolt di Medicina e Chirurgia A. Gemelli Corso di laurea in Terapia Occupazionale
Simone COBETTO GHIGGIA
l'antigene ai LT (Linfotici T) e cooperare con essi, vengono attivati chimicamente dalle citochine, cellule, dal maggior del numero di enzimi lisosomiali e dall'aumentata capacit di fagocitosi, rilasciano enzimi attivi sulla matrice extracellulare (metallosroteasi, elastasi e collagenasi),
matricola: 4051253 mail: simonecobettoghiggia@[Link] cell: 3775495873
dalle endotossine batteriche e dai mediatori chimici e fisicamente dall'aumento di dimensioni delle
molecole antibatteriche (fosfatasi, losozima e fosfolipasi), fattori della cascata del complemento (IL-12) e della coagulazione, citochine pro-infiammatoria (IL-1 e IL-6), agenti chemiotattici (chemochine), mediatori con azione anti-infiammatoria (IL-10), agenti che modulano l'infiammazione e fattori di crescita cellulare; LINFOCITI B e T, stimolati dagli antigeni, sono in stretta relazione con i macrofagi e utilizzano diverse coppie di molecole di adesione e citochine per migrare nelle sedi dell'infiammazione; PLASMACELLULE, ovvero LB ATTIVATI (Linfociti B) che producono anticorpi diretti contro gli antigeni presenti nella sede dell'infiammazione e contro le componenti tissutali modificate; MASTOCITI, che hanno il fine di produrre citochine (per contribuire alla fibrosi) ed esprimere il recettore che lega la porzione Fc delle IgE; GRAN EOSINOFILI, in gran quantit nelle reazioni mediate da IgE (Immunoglobuline di tipo E) e durante le infezioni parassitarie perch al loro interno contengono una proteina basica molto tossica per i parassiti; GRAN EOSINOFILI. - TIPI L'INFIAMMAZIONE CRONICA GRANULOMATOSA un processo cronico distinto che ha come cellule predominanti i MACROFAGI ATTIVI e che presente in un numero limitato di malattie giganti, formate da 20 nuclei). cronico-infettive e cronico-immunitarie (spesso i macrofagi attivi si uniscono a formare le cellule
Il GRANULOMA un'area circoscritta di infiammazione granulomatosa che pu essere acuta o cronica, formata da macrofagi con aspetto epiteloide, rivestiti da linfociti e plasmacellule. Il granuloma da corpo estraneo NON immunologico, non vivente ed inerte, risulta agenti viventi, in questo caso l'immunit mediata da LT (Linfociti T).
eccessivamente grosso per essere fagocitato, mentre il granuloma immunologico causato da
Oltre la precedente vi l'INFIAMMAZIONE CRONICA NON GRANULOMATOSA .
Potrebbero piacerti anche
- 01 Fisiologia Degli Apparati IntroNessuna valutazione finora01 Fisiologia Degli Apparati Intro26 pagine
- Fisiologia - Berne Levy, Riassunti Cap.12-13 Muscolare100% (13)Fisiologia - Berne Levy, Riassunti Cap.12-13 Muscolare10 pagine
- La Fisiopatologia Muscolare - DefNessuna valutazione finoraLa Fisiopatologia Muscolare - Def28 pagine
- 30 - Anatomia II - 26-04-2017 - RNessuna valutazione finora30 - Anatomia II - 26-04-2017 - R11 pagine
- Dott. Buzzi Ortopedia - Ginocchio PDFNessuna valutazione finoraDott. Buzzi Ortopedia - Ginocchio PDF173 pagine
- L'apparato Locomotore: Il Sistema Scheletrico, Articolare, MuscolareNessuna valutazione finoraL'apparato Locomotore: Il Sistema Scheletrico, Articolare, Muscolare64 pagine
- Lezione 3 - Biomeccanica Del GinocchioNessuna valutazione finoraLezione 3 - Biomeccanica Del Ginocchio40 pagine
- Fisiologia Renale (Rene, Acido-Base, Liquidi e Sangue)100% (4)Fisiologia Renale (Rene, Acido-Base, Liquidi e Sangue)30 pagine
- Tutte Le Differenziazioni Cominciano Fuori Dalla Cellula e Dagli OrganiNessuna valutazione finoraTutte Le Differenziazioni Cominciano Fuori Dalla Cellula e Dagli Organi4 pagine
- Analisi Del Passo (Fisioterapia, Scienze Motorie)Nessuna valutazione finoraAnalisi Del Passo (Fisioterapia, Scienze Motorie)13 pagine
- Fisiologia Medica NEUROFISIOLOGIA (Libro)Nessuna valutazione finoraFisiologia Medica NEUROFISIOLOGIA (Libro)44 pagine
- Nuova Dispensa Cliniche Chirurgiche AK 2021-2022Nessuna valutazione finoraNuova Dispensa Cliniche Chirurgiche AK 2021-2022239 pagine
- Patologia Mariotti - Del Sole - Biochimica-MicrobiologiaNessuna valutazione finoraPatologia Mariotti - Del Sole - Biochimica-Microbiologia216 pagine
- (A) Lezioni Patologia Generale - Generalità, Patologia Cellulare, Cancro PDFNessuna valutazione finora(A) Lezioni Patologia Generale - Generalità, Patologia Cellulare, Cancro PDF111 pagine